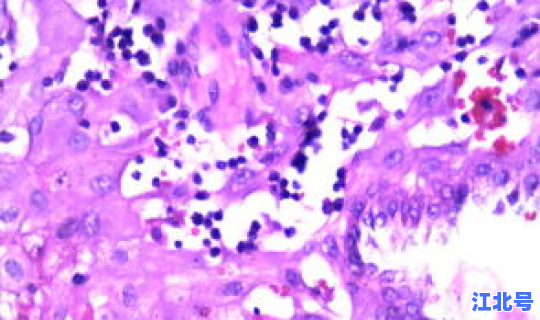
现在江苏出省要做核酸检测吗 hpv核酸检测多久出结果

现在的话 ,江苏东台还是需要核酸检测1.厦门春节隔离政策
自6月15日起,凡是有北京高风险区域活动史的,来厦(返厦)后须集中医学观察14天,有中风险区域活动史的人员须集中或居家医学观察14天。凡是从中高风险区域来厦的人员除隔离外 ,还必须提供“1+1 ”(1次核酸检测+1次血清抗体检测)检测证明,无法提供者入厦时需接受检测 。解除医学观察前1天再进行1次核酸检测,检测合格后可解除观察。从北京非中高风险地区来厦(返厦)的鼓励进行新冠肺炎病毒核酸检测。
22.山东春节隔离政策
对5月30日以来有高风险街道(乡镇)所在城区的其他街道(乡镇)以及中风险街道(乡镇)旅居史的入鲁返鲁人员进行摸排登记 ,实行14天居家隔离,进行2次核酸检测(抵达第1天和第13天)和1次血清抗体检测(抵达第13天),管理期限自抵达山东省内目的地起开始计算。
对5月30日以来有中风险街道(乡镇)所在城区的其他街道(乡镇)旅居史的入鲁返鲁人员进行摸排登记 ,实行14天健康监测,进行2次核酸检测(抵达第1天和第13天)和1次血清抗体检测(抵达第13天),监测期限自抵达山东省内目的地起开始计算 。
对5月30日以来有疫情重点地区低风险区旅居史的入鲁返鲁人员进行摸排登记 ,在鲁住宿的,于抵达当日进行1次核酸检测;不住宿的,个人做好自我健康监测 ,一旦出现发热 、咳嗽、腹泻等可疑症状,立即报告并就医排查。
23.河南春节隔离政策
来自中、高风险地区人员,集中隔离14天,做核酸检测(2次)和血清检测(1次)。低风险目前还没有要求 ,建议向社区报备 。
24.湖南春节隔离政策
高风险地区人员必须集中隔离14天并进行核酸检测,呈阴性后即可凭健康码通行;中风险地区人员需要先向社区或酒店报备,进入长沙后需先到集中隔离点进行核酸检测 ,呈阴性后即可凭健康码通行;低风险地区人员持健康码,体温检测正常即可通行。
25.重庆春节隔离政策
对高风险地区来渝返渝人员实行14天集中隔离医学观察,对中风险地区来渝返渝人员实行14天居家医学观察。同时做到发现疫情2小时报告、12小时完成核酸检测 、24小时完成流调 。
26.四川春节隔离政策
自6月14日起 ,来自北京市高风险地区(街道或乡镇)的入(返)川人员均须实行14天集中隔离医学观察,来自北京市中风险地区(街道或乡镇)的入(返)川人员均须实行14天居家医学观察。
来自北京高风险地区人员必须集中隔离并做核酸检测;来自北京中风险地区人员需居家隔离14天或集中隔离,并做核酸检测;来自低风险地区人员可直接进入成都 ,需提前向酒店或社区报备。
27.贵州春节隔离政策
中高风险地区人员需提供绿色健康码和7天内核酸检测阴性结果,到贵州省后再做一次核酸检测,结果呈阴性后即可放行 ,不再隔离;若无法提供绿码和7天内核酸检测结果,进入贵州后集中隔离14天,其间需要做两次核酸检测 。低风险地区人员只需提供绿码,体温正常即可放行。
28.云南春节隔离政策
无国外旅居史且无中转地 ,来自低风险地区人员可直接通行;来自中风险地区人员需提供健康证明,若健康码是绿码则可以通行,若提供不了则要进行核酸检测 ,结果呈阴性后可以放行;来自高风险地区人员必须集中观察14天,做2次核酸检测后呈阴性即可放行。
29.西藏春节隔离政策
目前,上海已经被排除高风景区的都是属于低风险区 ,所以都不需要核酸检测的 。除非后期又有新的情况发生变化。
2021上海出入需要核酸检测吗?
以目的地要求为准。不过,根据国家疾病预防控制局发布的《冬春季农村地区新冠肺炎疫情防控工作方案》,持核酸检测阴性证明返乡从1月28日当日春运开始后实施 ,至3月8日春运结束后截止。上海出入有关核酸检测,为大家梳理如下:
1.出上海需要做核酸检测吗?
如果你从上海跨省返回老家需要做核酸检测,比如从上海回长沙是必须要做核酸检测的 ,因为属于跨省返乡人员 。
2.入上海需要做核酸检测吗?
也需要做核酸检测。现在上海疫情管控的比较严格,返回上海后需要进行14天居家健康监测,做好体温、症状监测,非必要不外出 、不聚集 ,必须外出时做好个人防护。
1、强化闭环管理,着力完善人物同防“防控链”
对入境人员继续从严落实核酸检测 、受控转运、隔离管控、健康监测等措施,对进口冷链食品口岸查验 、交通运输、掏箱入库、批发零售等关键环节实施预防性全面消毒处理 ,加强发热门诊管理,落实商场 、超市、农贸市场、交通场站等公共场所疫防措施,针对性加强学校、养老机构 、监所等场所防护 。
2、强化流调追踪 ,着力完善病毒传播“溯源链”
定期对特定服务场所和从业人员开展核酸检测或抽检,对回皖在外务工人员全部落实核酸检测,一旦出现确诊病例和无症状感染者 ,迅速组织流调。
3、要强化能力建设,着力完善应急处置“保障链”
加强预案准备 、物资储备,做好专业救治人员、医疗物资、备用医院和隔离场所准备 ,增强医疗机构 、疾控机构检测能力,提高疫情处置应对水平。
4、要强化协调联动,着力完善疫情防控“责任链 ” 。
各级党委、政府要扛起政治责任,有关部门要各司其职 ,严格落实疫情直报机制,深入开展爱国卫生运动,动员全省上下在常态化疫情防控条件下 ,扎实做好“六稳”“六保”工作,认真谋划“十四五 ”发展,确保完成全年目标任务。
5 、在完善病毒传播“溯源链”中 ,安徽要求对回皖在外务工人员全部落实核酸检测。
2022年2月28日
12306核酸新规定、通知:
对于低风险地区,想要购买火车票 、高铁票的人员在进站乘车时不需要出示48小时内核酸检测阴性报告 。对于中高风险地区,想要购买火车票、高铁票的人员在进站乘车时必须出示48小时核酸检测阴性报告。
想了解自己所在地或目的地是否属于中高风险地区的朋友 ,可以在微信公众号【车主指南】回复【风险地区】,实时查询最新风险地区,每天更新!
截至2022年2月28日 ,我国
高风险地区(总数量8个):内蒙古自治区呼和浩特市(新城区2个、赛罕区1个、武川县1个 、回民区1个、土默特左旗1个)、天津市滨海新区1个 、广东省东莞市大朗镇1个,以上地区疫情一时之间无法快速恢复,因此在疫情结束前,建议非必要情况不要乘坐高铁前往该地区。
中风险地区(总数量193个):内蒙古自治区呼伦贝尔市满洲里市(1个)、包头市(8个)和呼和浩特市(97个)、黑龙江省鸡西市鸡东县(3个) 、江苏省苏州市吴中区(13个)、相城区(6个)、姑苏区(6个) 、吴江区(5个)、常熟市(2个)、张家港市(7个)和苏州工业园(16个) 。
还有湖北省武汉市江岸区(2个) 、武昌区(1个)、青山区(1个)和东湖高新区(1个)、广东省深圳市罗湖区(2个)、南山区(2个)和龙岗区(2个) 、广西壮族自治区防城港市防城区(2个)、四川成都市金牛区(1个)、温江区(1个) 、金堂县(1个)、高新区(7个)和天府新区(4个)、云南省临沧市镇康县(1个) 、云南省红河哈尼族彝族自治州河口瑶族自治县(2个)。
无论是上述哪一个中高风险地区的人员 ,在进高铁站(火车站)时,都需要出示48小时内核酸检测阴性证明以及“健康码”绿码,对于不能出示核酸检测证明 ,又或者持有“健康码 ”黄码、红码的人员不可以进高铁站(火车站)。
南京坐火车低风险地区,不需要做核酸检测,中高风险地区坐火车需要核酸检测。另外 ,从12306网站获悉,受疫情影响,近期出行的乘客开始担心 ,乘火车要不要提供核酸检测报告 。自疫情发生以来,铁路部门没有这方面的要求。
核酸检测要根据以下步骤来进行:
1 、首先要自我反省最近是否有疫情发现地区的活动史,或者有有没有可疑发热病人、确诊患者的接触史。如果都没有以上流行病学史 ,也没有发热、乏力 、干咳等症状时,可以在公众号或者是小程序,或者电话预约 。
2、在做核酸检测的时候需要注意,要戴好口罩与陌生人保持一米以上的距离。
3、做核酸检测要先登记身份证信息 ,如实报告流行病学史。
4、到医疗机构做核酸检测的时候,要注意医生会让患者张开嘴巴,在扁桃体或咽后壁用棉签轻轻的一抹取出分泌物 。这时候可能会有干呕 、咳嗽等症状 ,最好是忍住。
5、医生取完标本后,会把棉签放到专门的试剂盒以及及时的低温保存送检。要关注核酸检测的结果如何查询,以及核酸检测结果出具的时间 。